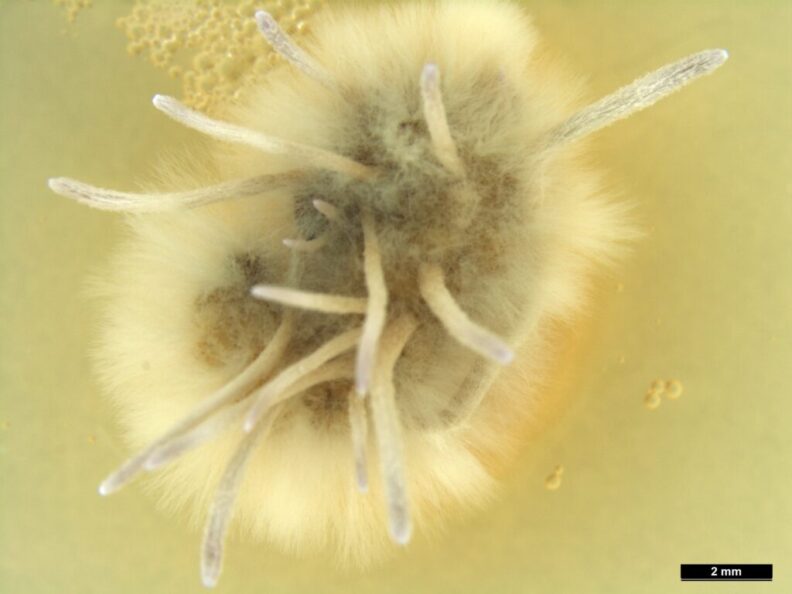

Students use AI to learn about the future of farming
Students at the 95th annual Washington Future Farmers of America State Convention and Expo held earlier this month on the Washington State University campus learned about computer science, robotics, and technological […]